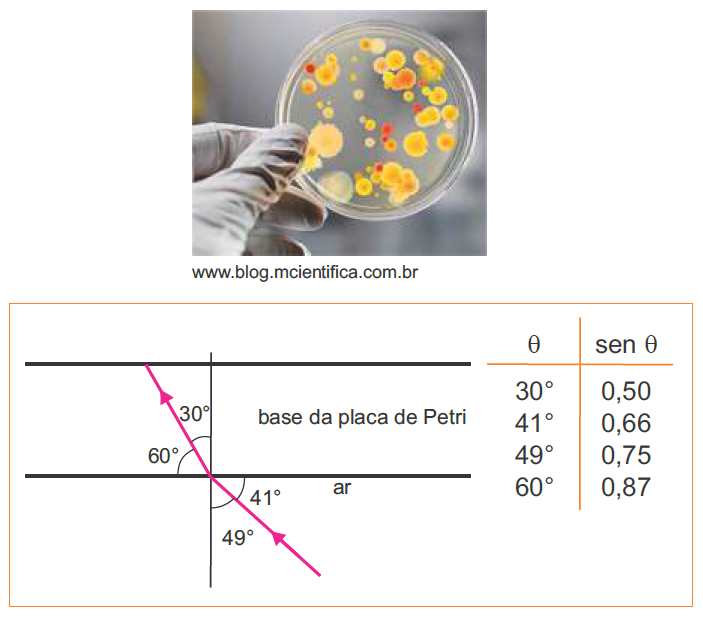

FACULDADE ISRAELITA DE MEDICINA ALBERT EINSTEIN
PROVAS ANTERIORES
2020
FACULDADE DE MEDICINA – ALBERT EINSTEIN – 2020 – PROVA 1
FACULDADE DE MEDICINA – ALBERT EINSTEIN – 2020 – PROVA 2
FALCULDADE DE MEDICINA – ALBERT EINSTEIN – 2020 – GABARITO
2019
FACULDADE DE MEDICINA – ALBERT EINSTEIN – 2019 – GABARITO
FACULDADE DE MEDICINA – ALBERT EINSTEIN – 2019 – PROVA 1
FACULDADE DE MEDICINA – ALBERT EINSTEIN – 2019 – PROVA 2
2018
Faculdade de Medicina – Albert Einstein – 2018 verão
Faculdade de Medicina – Albert Einstein – 2018 verão – gabarito
2017
Faculdade de Medicina – Albert Einstein – 2017 inverno
Faculdade de Medicina – Albert Einstein – 2017 inverno – gabarito
Faculdade de Medicina – Albert Einstein – 2017 verão
Faculdade de Medicina – Albert Einstein – 2017 verão – gabarito
2016
Faculdade de Medicina – Albert Einstein – 2016 inverno
Faculdade de Medicina – Albert Einstein – 2016 inverno – gabarito
Faculdade de Medicina – Albert Einstein – 2016 verão
Faculdade de Medicina – Albert Einstein – 2016 verão – gabarito
MAPA DE CLASSIFICAÇÃO
2018
QUÍMICA
| 6 – FUNÇÕES OXIGENADAS E NITROGENADAS |
| 7 – O ESTADO GASOSO |
| 8 – TERMOQUÍMICA |
| 9 – CINÉTICA QUÍMICA |
| 10 – ESTEQUIOMETRIA |
FÍSICA
| 21 – FORÇA MAGNÉTICA |
| 22 – LENTES ESFÉRICAS |
| 23 – GASES |
| 24 – ATRITO |
| 25 – EFEITO JOULE |
2017-2
FÍSICA
| 6 – INTRODUÇÃO À ONDAS |
| 7 – ESTÁTICA DO CORPO EXTENSO |
| 8 – HIDROSTÁTICA |
| 9 – CALORIMETRIA |
| 10 – FORÇA MAGNÉTICA |
2017-1
FÍSICA
| 6 – ESPELHOS PLANOS |
| 7 – RESISTORES |
| 8 – LANÇAMENTO OBLÍQUO |
| 9 – FORÇA ELÉTRICA |
| 10 – CALORIMETRIA |
2016-2
FÍSICA
| 6 – POTÊNCIA E ENERGIA ELÉTRICA |
| 7 – INTRODUÇÃO À ONDAS |
| 8 – CAMPO MAGNÉTICO |
| 9 – FENÔMENOS ONDULATÓRIOS |
| 10 – TRABALHO |
2016-1
FÍSICA
| 6 – MRU |
| 7 – ONDAS ESTACIONÁRIAS |
| 8 – LENTES |
| 9 – POTÊNCIA E ENERGIA ELÉTRICA |
| 10 – EFEITO JOULE |
QUÍMICA NO EINSTEIN
QUÍMICA GERAL
- a) 213,7 g.
- b) 196,5 g.
- c) 512,8 g.
- d) 17,1 g.
(O ESTADO GASOSO) D (FACULDADE DE MEDICINA ALBERT EINSTEIN 2018) Alguns balões foram preenchidos com diferentes gases. Os gases utilizados foram o hélio, o gás carbônico,o metano e o hidrogênio. A massa molar aparente do ar é 28,96 g/mol e, segundo a Lei de Graham, a velocidade com que um gás atravessa uma membrana é inversamente proporcional à raiz quadrada de sua massa molar.
- a) metano e hidrogênio.
- b) hélio e gás carbônico.
- c) metano e hélio.
- d) gás carbônico e hidrogênio.
FÍSICO QUÍMICA
(TERMOQUÍMICA) A (FACULDADE DE MEDICINA ALBERT EINSTEIN 2018) Observe a equação de formação de etanol a seguir:
Com base nas equações abaixo que resultam na reação de interesse, calcule o ∆H da reação de formação do etanol.
- a) -278 kJ/mol.
- b) -2048 kJ/mol.
- c) -688 kJ/mol.
- d) +294 kJ/mol.
Sobre a influência do aumento da temperatura para a formação do complexo ativado e na rapidez das reações químicas foram feitas as afirmações abaixo- Com o aumento da temperatura, um maior número de moléculas irá possuir energia suficiente para atingir o estado de ativação.
- O aumento da temperatura aumenta o número de colisões entre as moléculas dos reagentes e, consequentemente, aumentam os choques não eficazes e os eficazes.
- Para que ocorra a formação do complexo ativado, as moléculas dos reagentes devem possuir uma quantidade de energia no mínimo igual à energia de ativação e, portanto, o aumento de temperatura favorece a formação do complexo ativado.
- A formação do complexo ativado ocorre apenas em reações endotérmicas.
- a) Apenas I.
- b) I e II.
- c) I, II, e III.
- d) Todas.
QUÍMICA ORGÂNICA
- Apresenta as funções orgânicas fenol e éster.
- Possui três radicais metil e 1 radical pentil.
- Possui três anéis aromáticos condensados.
- É uma cadeia insaturada e ramificada.
- a) I e II.
- b) II e III.
- c) II e IV.
- d) I e IV.
FÍSICA NO EINSTEIN
MECÂNICA
(MRU) A (FACULDADE DE MEDICINA ALBERT EINSTEIN 2016-1)
Jetpack para corredores os fará correr 1,6 km em quatro minutos
Trata-se do 4 Minute Mile (4MM), um acessório capaz de aumentar a velocidade de corrida de uma pessoa que esteja a pé. Foi desenvolvido por estudantes da Arizona State University.
Enquanto pesquisava próteses para amputados, a equipe notou que poderia trabalhar no design de um protótipo que ajudasse o ser humano a correr mais rápido. Como aplicar as forças? Até mesmo um exoesqueleto foi pensado para gerar a força necessária para aumentar a velocidade, mas o resultado final foi o Jetpack.
Como o nome sugere, o objetivo é fazer com que seja possível correr uma milha (aproximadamente 1,6 km) em quatro minutos. Os testes têm sido promissores. O tempo gasto por um atleta, usando o Jetpack, em corridas de 200 metros, foi 3 segundos mais rápido que o normal, mesmo carregando esse peso extra.
Outra ideia é usar o Jetpack em missões militares, como infiltrações e ofensivas que necessitem de rápido deslocamento. Por enquanto, o projeto ainda não passou da fase de protótipo.
Disponível em: http://www.tecmundo.com.br/. Adaptado.
Com base nas informações do texto, determine a velocidade média aproximada, em km/h, de uma pessoa que, usando o Jetpack 4MM, tenha percorrido uma milha dentro do tempo previsto pelos estudantes da Arizona State University.
- a) 2 4
- b) 6,7
- c) 5,0
- d) 0,5
(LANÇAMENTO OBLÍQUO) D (FACULDADE DE MEDICINA ALBERT EINSTEIN 2017-1) Na modalidade esportiva do salto à distância, o esportista, para fazer o melhor salto, deve atingir a velocidade máxima antes de saltar, aliando-a ao melhor ângulo de entrada no momento do salto que, nessa modalidade, é 45° . Considere uma situação hipotética em que um atleta, no momento do salto, alcance a velocidade de 43,2 km/h, velocidade próxima do recorde mundial dos 100 metros rasos, que é de 43,9 km/h. Despreze o atrito com o ar enquanto ele está em “vôo” e considere o saltador como um ponto material situado em seu centro de gravidade. Nessas condições, qual seria, aproximadamente, a distância alcançada no salto?
Adote o módulo da aceleração da gravidade igual a 10 m/s2 .
Dados: sen 45° = cos 45° = 0,7
- a) 7 m
- b) 10 m
- c) 12 m
- d) 14 m
(ATRITO) B (FACULDADE DE MEDICINA ALBERT EINSTEIN 2018) Um bloco é lançado com velocidade inicial v0, em movimento ascendente, num longo plano inclinado que forma um ângulo Ɵ com a direção horizontal. O coeficiente de atrito cinético entre as superfícies do bloco e do plano vale μ e o módulo da aceleração da gravidade local vale g. A expressão algébrica que possibilita determinar a máxima distância percorrida pelo bloco durante a subida e o respectivo tempo gasto nesse deslocamento é:
(TRABALHO DE UMA FORÇA) B (FACULDADE DE MEDICINA ALBERT EINSTEIN 2016) A imagem abaixo é de uma cama hospitalar manual com três manivelas acopladas ao leito, que permitem diversos tipos de elevações. Com base na descrição do fabricante, determine o módulo aproximado da força, supostamente constante, exercida por uma pessoa que desenvolve uma potência de 38,5 W, na extremidade da manivela central,responsável pela elevação horizontal do leito, para que consiga elevar uma pessoa com massa correspondente ao máximo suportado na especificação, desde a altura mínima até a altura máxima. Sabe-se que cada volta completa, de perímetro igual a 1,8 m, corresponde a uma elevação de 70 mm.
Dado: Módulo da aceleração da gravidade (g) = 10 m.s-2.
- a) 38,5 N
- b) 42,8 N
- c) 110,0 N
- d) 385,0 N
(ESTÁTICA DO CORPO EXTENSO) C (FACULDADE DE MEDICINA ALBERT EINSTEIN 2017-2) Uma bailarina de massa 50 kg encontra-se apoiada em um dos pés num dos extremos de uma viga retangular de madeira cuja distribuição da massa de 100 kg é homogênea. A outra extremidade da viga encontra-se ligada a um cabo de aço inextensível, de massa desprezível e que faz parte de um sistema de polias, conforme a figura.
Sabendo que o sistema encontra-se em equilíbrio estático, determine, em unidades do SI, a massa M que está suspensa pelo sistema de polias.
- a) 125
- b) 600
- c) 1000
- d) 2500
(HIDROSTÁTICA) A (FACULDADE DE MEDICINA ALBERT EINSTEIN 2017-2) Um caminhão tanque, estacionado sobre um piso plano e horizontal, tem massa de 12 toneladas quando o tanque transportador, internamente cilíndrico, de raio interno 1 m, está totalmente vazio. Quando esse tanque está completamente cheio de combustível, ele fica submetido a uma reação normal do solo de 309.600 N.

Com base nessas informações e nas contidas no gráfico, referentes ao combustível transportado, determine o comprimento interno do tanque cilíndrico, em unidades do SI. Suponha invariável a densidade do combustível em função da temperatura.
• valor de pi: π = 3
• módulo da aceleração da gravidade: 10 m.s–2
- a) 8
- b) 10
- c) 12
- d) 15
TERMOLOGIA
(CALORIMETRIA) C (FACULDADE DE MEDICINA ALBERT EINSTEIN 2017-2) Nos veículos com motores refrigerados por meio líquido, o aquecimento da cabine de passageiros é feito por meio da troca de calor entre o duto que conduz o líquido de arrefecimento que circula pelo motor e o ar externo. Ao final, esse ar que se encontra aquecido, é lançado para o interior do veículo.

Num dia frio, o ar externo, que está a uma temperatura de 5 °C, é lançado para o interior da cabine, a 30 °C, a uma taxa de 1,5 L/s. Determine a potência térmica aproximada, em watts, absorvida pelo ar nessa troca de calor.
• densidade do ar: 1,2 kg/m3
• calor específico do ar: 0,24 cal.g–1 °C–1
• 1cal = 4,2 J
- a) 20
- b) 25
- c) 45
- d) 60
(CALORIMETRIA) B (FACULDADE DE MEDICINA ALBERT EINSTEIN 2017-1) Sabe-se que um líquido possui calor específico igual a 0,58 cal/g. °C . Com o intuito de descobrir o valor de seu calor latente de vaporização, foi realizado um experimento onde o líquido foi aquecido por meio de uma fonte de potência uniforme, até sua total vaporização, obtendo-se o gráfico abaixo. O valor obtido para o calor latente de vaporização do líquido, em cal/g, está mais próximo de:
- a) 100
- b) 200
- c) 540
- d) 780
(GASES) A (FACULDADE DE MEDICINA ALBERT EINSTEIN 2018) A bomba de ar para bicicleta da figura possui 50,0 cm de comprimento interno para o deslocamento do pistão. Quando acoplada à câmara de ar totalmente vazia do pneu de uma bicicleta e com o pistão recuado de 45,0 cm, medido a partir da base da bomba, a pressão interna do ar é de 1,0 atm. Quando o ar é injetado sob pressão, em uma válvula tipo Schrader da câmara de ar, a força exercida pelo seu fluxo vence a força de retenção de uma mola, abrindo o obturador e permitindo sua entrada (veja a figura).
- a) 7,5
- b) 9,0
- c) 15,0
- d) 37,5
ONDAS
(INTRODUÇÃO À ONDAS) B (FACULDADE DE MEDICINA ALBERT EINSTEIN 2017-2) Definimos o intervalo (i) entre dois sons, como sendo o quociente entre suas frequências, i=f2/f1. Quando i=1, dizemos que os sons estão emuníssono; quando i=2, dizemos que o intervalo corresponde a uma oitava acima; quando i=0,5, temos um intervalo correspondente a uma oitava abaixo. Considere uma onda sonora de comprimento de onda igual a 5 cm, propagando-se no ar com velocidade de 340 m/s. Determine a frequência do som, em hertz, que corresponde a uma oitava abaixo da frequência dessa onda.
- a) 340
- b) 3400
- c) 6800
- d) 13600
(INTRODUÇÃO À ONDAS) D (FACULDADE DE MEDICINA ALBERT EINSTEIN 2016) Pesquisas odontológicas buscam por modalidades adjuvantes de tratamento antimicrobiano com menor possibilidade de efeitos colaterais para o indivíduo. Oscar Raab, em 1900, observou a morte de microorganismos quando expostos à luz solar e ao ar, na presença de certos corantes, o que seria o princípio de uma nova modalidade clínica conhecida como Terapia Fotodinâmica (TFD). A fotossensibilização depende do corante utilizado, da sua concentração, fluência e intensidade de potência do laser, e da espécie bacteriana envolvida. Para ativar as substâncias fotossensibilizadoras responsáveis pelo processo fotodinâmico, é necessário o uso de luz com frequência ressonante com o nível de absorção óptica da referida substância. Para o processo fotodinâmico, a luz ideal deve ter densidade de potência adequada e ser colimada. A alta colimação dos feixes laser somados às altas densidades de potência fazem desse o equipamento ideal para a ativação. Lasers sólidos tipo Nd:YAG têm sido empregados mais recentemente, mas ainda apresentam elevado custo. No entanto, empregando-se lasers Nd:YAG, associados a alguns dispositivos ópticos, obtêm-se feixes de laser na faixa de 200 a 2 000 nm, o que atende boa parte dos agentes fotossensibilizadores do mercado.
https://www.metodista.br/revistas/revistas-unimep/index.php/FOL/ article/viewArticle/248(adaptado) Acessado em: 27/03/2016
Dados: 1 nanômetro (1nm) = 1.10-9 m; velocidade da luz no ar ( c ) = 300.000 km/s.
Considerando-se a faixa dos tipos de feixes de lasers obtidos empregando-se lasers sólidos Nd:YAG, concluímos que as frequências produzidas estão na região compreendida entre:
- a) Luz visível e ultravioleta
- b) Infravermelho e luz visível
- c) Micro-ondas e raios-X
- d) Infravermelho e ultravioleta
(FENÔMENOS ONDULATÓRIOS) B (FACULDADE DE MEDICINA ALBERT EINSTEIN 2016) A placa de Petri é um recipiente cilíndrico, achatado, de vidro ou plástico, utilizado para cultura de micro-organismos e constituída por duas partes: uma base e uma tampa. Em laboratórios de microbiologia e rotinas de bacteriologia, as placas de Petri são usadas para a identificação de micro-organismos. Num ensaio técnico, um laboratorista incide um feixe de luz monocromática de comprimento de onda igual a 600 nm que, propagando-se inicialmente no ar, incide sobre a base de uma placa de Petri, conforme esquematizado na figura abaixo. Determine o índice de refração (n) do material da placa de Petri em relação ao ar, o comprimento (λ) e a frequência (f) da onda incidente enquanto atravessa a base da placa.
Dado: Índice de refração do ar (nar) = 1,0.
- a) 0,76 ; 790 nm ; 5,0.1014 Hz
- b) 1,50 ; 400 nm ; 5,0.1014 Hz
- c) 1,50 ; 600 nm ; 3,3.1014 Hz
- d) 1,32 ; 400 nm ; 7,5.1014 Hz
(ONDAS ESTACIONÁRIAS) C (FACULDADE DE MEDICINA ALBERT EINSTEIN 2016-1) Em 1816 o médico francês René Laënnec, durante um exame clínico numa senhora, teve a ideia de enrolar uma folha de papel bem apertada e colocar seu ouvido numa das extremidades, deixando a outra livre para ser encostada na paciente. Dessa forma, não só era evitado o contato indesejado com a paciente, como os sons se tornavam muito mais audíveis. Estava criada assim a ideia fundamental do estetoscópio [do grego, “stêthos” (peito) “skopéo” (olhar)].
É utilizado por diversos profissionais, como médicos e enfermeiros, para auscultar (termo técnico correspondente a escutar) sons vasculares, respiratórios ou de outra natureza em diversas regiões do corpo.
É composto por três partes fundamentais. A peça auricular tem formato anatômico para adaptar-se ao canal auditivo. Os tubos condutores do som a conectam à peça auscultatória. E, por fim, a peça auscultatória, componente metálico colocado em contato com o corpo do paciente. Essa peça é composta por uma campânula, que transmite melhor os sons de baixa frequência – como as batidas do coração – e o diafragma, que transmite melhor os sons de alta frequência, como os do pulmão e do abdômen.
A folha de papel enrolada pelo médico francês René Laënnec pode ser interpretada como um tubo sonoro aberto. Considerando o comprimento desse tubo igual a 34cm e que, ao auscultar um paciente, houve a formação, no interior desse tubo, de uma onda estacionária longitudinal de segundo harmônico e que se propagava com uma velocidade de 340 m/s, qual a frequência dessa onda, em hertz?
- a) 250
- b) 500
- c) 1000
- d) 2000
ÓPTICA
(ESPELHOS PLANOS) C (FACULDADE DE MEDICINA ALBERT EINSTEIN 2017-1) Um pequeno boneco está diante de um espelho plano, conforme a figura abaixo. Em relação à imagem conjugada pelo espelho, podemos classificá-la como tendo as seguintes características:
- a) real, direita e do mesmo tamanho do objeto.
- b virtual, invertida lateralmente e maior que o objeto.
- c) virtual, direita e do mesmo tamanho do objeto.
- d) real, invertida lateralmente e do mesmo tamanho do objeto.
(LENTES DELGADAS ESFÉRICAS) C (FACULDADE DE MEDICINA ALBERT EINSTEIN 2018) Um objeto real de 10 cm de altura é posicionado a 30 cm do centro óptico de uma lente biconvexa, perpendicularmente ao seu eixo principal. A imagem conjugada tem 2,5 cm de altura. Para produzirmos uma imagem desse mesmo objeto e com as mesmas características, utilizando, porém, um espelho esférico, cujo raio de curvatura é igual a 20 cm, a que distância do vértice, em cm, da superfície refletora do espelho ele deverá ser posicionado, perpendicularmente ao seu eixo principal?
- a) 20
- b) 25
- c) 50
- d) 75
(LENTES DELGADAS ESFÉRICAS) B (FACULDADE DE MEDICINA ALBERT EINSTEIN 2016-1) Uma estudante de medicina, dispondo de espelhos esféricos gaussianos, um côncavo e outro convexo, e lentes esféricas de bordos finos e de bordos espessos, deseja obter, da tela de seu celular, que exibe a bula de um determinado medicamento, e aqui representada por uma seta, uma imagem ampliada e que possa ser projetada na parede de seu quarto, para que ela possa fazer a leitura de maneira mais confortável. Assinale a alternativa que corresponde à formação dessa imagem, através do uso de um espelho e uma lente, separadamente.
ELETRICIDADE
(FORÇA ELÉTRICA) A (FACULDADE DE MEDICINA ALBERT EINSTEIN 2017-1) Observe a figura abaixo onde duas esferas de massas iguais a m estão eletrizadas com cargas elétricas Q, iguais em módulo, porém de sinais contrários. Estando o sistema em equilíbrio estático, determine a distância d entre os centros das esferas. Adote o módulo da aceleração da gravidade igual a g, a constante eletrostática do meio igual a k e a tração na corda igual a T.
(POTÊNCIA E ENERGIA ELÉTRICA) B (FACULDADE DE MEDICINA ALBERT EINSTEIN 2016-1)
Nobel de Física vai para 3 japoneses por iluminação a LED
Copenhague – Os japoneses Isamu Akasaki, Hiroshi Amano e Shuji Nakamura (foto), este último naturalizado americano, foram agraciados nesta terça-feira com o Prêmio Nobel de Física 2014 pela invenção, nos anos 90, do LED azul. A descoberta se inscreve no “espírito de Alfred Nobel” de fazer invenções que geram grande benefício à humanidade, afirmou o comitê do Nobel no Instituto Karolinska, em Estocolmo, na Suécia. Por muitos anos, a indústria teve à sua disposição LED de cor vermelha e verde. No entanto, para obter a luz branca, era necessário ter a componente azul. A importância vem do fato que era impossível criar lâmpadas com luz branca sem o uso do azul. “Para fazer qualquer coisa, você precisa das três cores primárias (vermelho, verde e azul). Vermelho era mais fácil por causa do arsenieto de gálio que já estava disponível, mas ninguém sabia como fazer o azul”, disse Nakamura em uma entrevista em 2009.
Disponível em: http://exame.abril.com.br/tecnologia/noticias/nobel-de-fisica-vai-para-3-japoneses-por-iluminacao-a-led. Adaptado.
Empolgado com a divulgação da notícia do prêmio Nobel de Física de 2014, o Sr. Piril Ampo resolve desembolsar R$ 60,00 e substituir a lâmpada incandescente de sua sala, cuja potência é de 100W e cujo custo de aquisição foi de R$ 5,00, por uma lâmpada com a tecnologia LED, de 9W, que tem o mesmo fluxo luminoso da lâmpada a ser substituída. Calcule após quantos dias consecutivos de uso, aproximadamente, o Sr. Piril Ampo terá recuperado a diferença entre os valores desembolsados pelas duas lâmpadas. Considere para as duas lâmpadas uma utilização diária de 7h e o custo do kWh de R$ 0,30.
- a) 873
- b) 288
- c) 2910
- d) 2091
(POTÊNCIA E ENERGIA ELÉTRICA) A (FACULDADE DE MEDICINA ALBERT EINSTEIN 2016) O Forno de Bier, um dos dispositivos mais antigos da termoterapia utilizados pela fisioterapia, é assim denominado em homenagem ao seu inventor Dr. August Bier. É um compartimento que se coloca por sobre a região a ser tratada, dentro do qual é gerado calor a partir de resistências elétricas. Consiste em uma peça confeccionada com flandre e madeira, em forma de semicilindro, aberto nas duas extremidades. Quando o paciente é introduzido no seu interior, cobre-se o equipamento com um cobertor de flanela, para que haja um mínimo de perda de calor do forno para o meio externo, através das aberturas existentes em suas extremidades. Uma faixa de aplicação confiável fica em torno de 45 a 60°C. Para que o efeito terapêutico seja atingido nos tecidos, é importante que o tempo de aplicação fique em torno de 20 a 30 minutos. Se em uma clínica de fisioterapia são realizadas 10 aplicações diárias, de 30 minutos cada uma, com o forno de Bier especificado ao lado em sua potência máxima, qual o custo mensal, em reais, para essa clínica, devido ao uso desse aparelho, considerando-se 21 dias úteis e o custo do kWh de R$ 0,20?
http://ucbweb.castelobranco.br/webcaf/arquivos/12851/4899/apostila_fisioterapia_geral.pdf. Acessado em: 27/03/2016 [Adaptado]
Dado: 1 quilovolt (1kV) = 1.103 V
- a) 31,50
- b) 63,00
- c) 157,50
- d) 1.500,00
(RESISTORES) A (FACULDADE DE MEDICINA ALBERT EINSTEIN 2017-1) O custo mensal referente ao uso diário de trinta minutos de um secador de cabelos, ao longo de um mês, é de R$ 3,60. Sendo o valor do kWh igual a R$ 0,20 e a tensão de funcionamento do aparelho igual a 110 V, determine o valor aproximado da resistência elétrica de seu resistor, em ohms. Considere desprezíveis as resistências elétricas dos fios de ligação e demais componentes do circuito interno do aparelho.
- a) 10
- b) 15
- c) 34
- d) 73
(EFEITO JOULE) D (FACULDADE DE MEDICINA ALBERT EINSTEIN 2018) Um recipiente contendo 1 litro de água, a 20 °C, é colocado no interior de um forno de micro-ondas. O aparelho é ligado a uma tensão de 110 V e percorrido por uma corrente elétrica de 10 A. Após 40 minutos, verifica-se que ainda resta ¼ de litro de água líquida no recipiente. Determine o rendimento percentual aproximado desse aparelho.
- a) 19
- b) 25
- c) 71
- d) 77
(EFEITO JOULE) C (FACULDADE DE MEDICINA ALBERT EINSTEIN 2016-1) Por decisão da Assembleia Geral da Unesco, realizada em dezembro de 2013, a luz e as tecnologias nela baseadas serão celebradas ao longo de 2015, que passará a ser referido simplesmente como Ano Internacional da Luz. O trabalho de Albert Einstein sobre o efeito fotoelétrico (1905) foi fundamental para a ciência e a tecnologia desenvolvidas a partir de 1950, incluindo a fotônica, tida como a tecnologia do século 21. Com o intuito de homenagear o célebre cientista, um eletricista elabora um inusitado aquecedor conforme mostra a figura abaixo. Esse aquecedor será submetido a uma tensão elétrica de 120 V, entre seus terminais A e B, e será utilizado, totalmente imerso, para aquecer a água que enche completamente um aquário de dimensões 30 cm x 50 cm x 80 cm. Desprezando qualquer tipo de perda, supondo constante a potência do aquecedor e considerando que a distribuição de calor para a água se dê de maneira uniforme, determine após quantas horas de funcionamento, aproximadamente, ele será capaz de provocar uma variação de temperatura de 36 °F na água desse aquário.
- a) 1,88
- b) 2,00
- c) 2,33
- d) 4,00
MAGNETISMO
(CAMPO MAGNÉTICO) A (FACULDADE DE MEDICINA ALBERT EINSTEIN 2016) Desde o aparecimento de sistemas artificiais de estimulação cardíaca, dotados de circuitos de sensibilidade (os marcapassos), tem-se observado sua relativa vulnerabilidade frente a interferências de diferentes naturezas, tanto em situações ambientais características do dia a dia do paciente portador de marcapasso, quanto em circunstâncias em que há a necessidade de submetê-lo a procedimentos terapêuticos envolvendo correntes elétricas, ondas eletromagnéticas ou radiações. Campos magnéticos da ordem de 17,5 μT são encontrados em regiões próximas a condutores de altas correntes como, por exemplo, alarmes antirroubo, detectores de metais, linhas de transmissão etc e podem inibir o gerador de estímulos cardíacos, mudando consequentemente seu comportamento.
Determine até que distância aproximada, em metros, de uma linha de transmissão muito comprida (condutor retilíneo), percorrida por uma corrente contínua de 217 A, a uma tensão de 400 kV, o campo magnético produzido teria magnitude capaz de poder alterar o comportamento do gerador de estímulos cardíacos. Adote: μ0= 4.π.10-7 T.m.A-1.
http://paginas.fe.up.pt/~mam/Linhas-01.pdf [Adaptado]
Dados: Pi (π) = 3; 1microtesla (1μT) = 1.10-6 T
- a) 2,48
- b) 4,96
- c) 17,5
- d) 24,8
- a) 1, repulsiva
- b) 3, atrativa
- c) 12, atrativa
- d) a resultante das forças será nula, portanto, não haverá interação entre elas.
(FORÇA MAGNÉTICA) D (FACULDADE DE MEDICINA ALBERT EINSTEIN 2017-2) Determine o valor da força magnética, em newtons, entre dois fios metálicos cilíndricos, de mesma resistividade elétrica, retilíneos, paralelos, de comprimentos iguais a 100 cm, distanciados em 10 cm e com raios de 1 mm e 2 mm, quando cada um deles for ligado a uma fonte de corrente contínua de diferença de potencial igual a 2,0 V.
Adote: ρ = 24 nΩ.m (resistividade elétrica do metal dos fios)
• permeabilidade magnética do meio: μ = 4 . π . 10–7 T.m/A
- a) 0,2
- b) 0,3
- c) 0,4
- d) 0,5